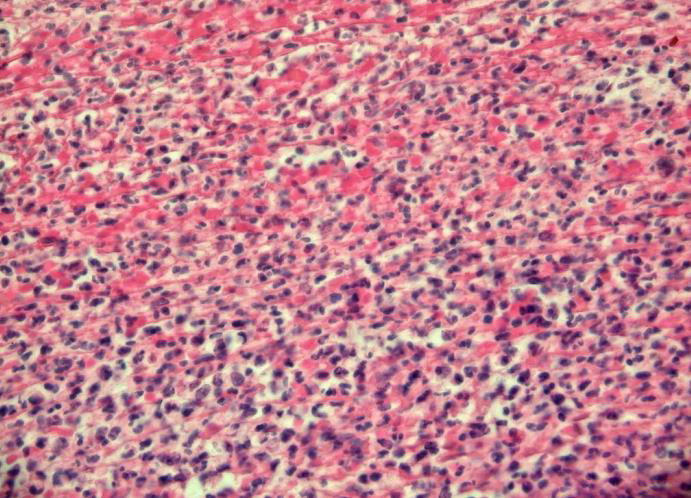
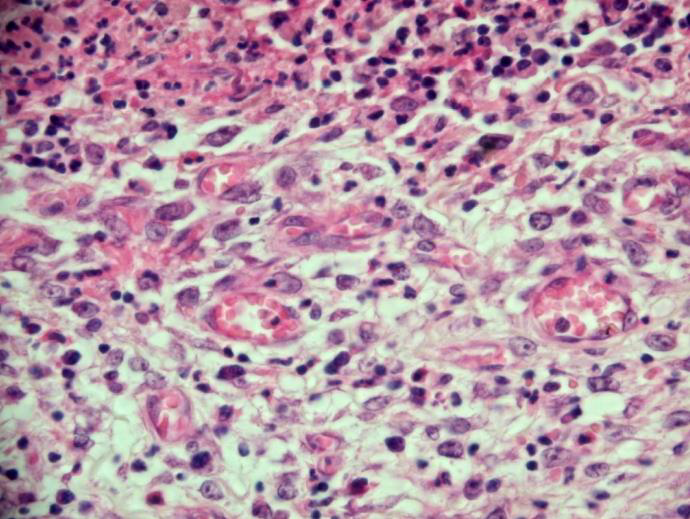

necrosis
- Coagulative necrosis
- Caseous necrosis
- Liquefactive necrosis

- Foam cells
- 黑圈,巨噬細胞因為吞很多lipid而使細胞質呈偏白的泡泡狀,稱為Foamy macrophage(Foam cells)

- Hemosiderin-laden macrophages
- 藍圈,吞噬Hemosiderin的 macrophage
- Hemosiderin
- 黑圈,紅血球分解後,含鐵成分聚集而成

{}
Caseous necrosis
- Macrophage
- 藍圈



langhans giant cell

Fat necrosis: 急性胰臟炎(acute pancreatitis)


Gangrenous necrosis

Adaptation
- metaplasia
- 化生
Squamocolumnar junction
stratified squamous epithelium


合成過多的分泌性蛋白:漿細胞分泌免疫球蛋白(immunoglobin)後儲存在細胞內形成Russell bodies

Dystrophic calcification

{}
肺泡壁分布是congestion,亂糟糟的就是hemorrhage

fat emboli

Inflammation and Repair
- angiogenesis
- 血管增生
- epithelioid cells
- 上皮細胞的活化巨噬細胞
acute appendicitis

ulcer, stomach

壁細胞(Parietal cell):紅色圓圓細胞,分泌HCL和intrinsic factor。
主細胞(Chief cell):藍紫色細胞,分泌蛋白酶。

- necrotic tissue(急性發炎細胞)
- granulation tissue
- fibrotic tissue
- lymphoid follicles

necrotic tissue
fibrotic tissue

granulation tissue
幽門腺黏膜 (pyloric gland)

intestinal metaplasia (Goblet cell)

Hemodynamic Disorders
若是血栓形成較久(右圖左),organization會較完整,則血栓內的顏色較淡、fibrin較多、有較多內皮細胞。要與congestion(右圖右,也就是剛形成的fresh thrombus)區分。

fibrin堆積形成的thrombus

Plasma 血漿

Hemorrhage

- Mesentery
- 腸繫膜
腸子的submucosa,edema

Neoplasia
- Teratoma
- 畸胎瘤
- adenoma
- 腺瘤
- desmoplasia
- 結締組織增生
- pleomorphism
- 多形性
adenocarcinom
desmoplasia(黃色星號)

- carcinoma in situ
- 原位癌,異常細胞僅存在於它們最初形成的細胞層中,沒有侵犯周圍組織。
Squamous cell carcinoma (SCC)
invade

carcinoma i situ

其他單字
Atherosclerosis
動脈粥狀硬化
Rupture
破裂
Aneurysm
動脈瘤
Stromal cell
基質細胞